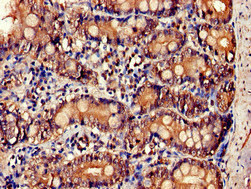

IL34 Antibody
-
中文名稱:IL34兔多克隆抗體
-
貨號:CSB-PA751146LA01HU
-
規格:¥440
-
圖片:
-
Western Blot
Positive WB detected in: PC-3 whole cell lysate
All lanes: IL34 antibody at 4µg/ml
Secondary
Goat polyclonal to rabbit IgG at 1/50000 dilution
Predicted band size: 28 kDa
Observed band size: 28 kDa -
Immunohistochemistry of paraffin-embedded human small intestine tissue using CSB-PA751146LA01HU at dilution of 1:100
-
-
其他:
產品詳情
-
產品名稱:Rabbit anti-Homo sapiens (Human) IL34 Polyclonal antibody
-
Uniprot No.:
-
基因名:
-
別名:C16orf77 antibody; Chromosome 16 open reading frame 77 antibody; FPT025 antibody; IL 34 antibody; IL-34 antibody; Il34 antibody; IL34_HUMAN antibody; Interleukin 34 antibody; Interleukin-34 antibody; Interleukin34 antibody; MGC34647 antibody
-
宿主:Rabbit
-
反應種屬:Human
-
免疫原:Recombinant Human Interleukin-34 protein (191-240AA)
-
免疫原種屬:Homo sapiens (Human)
-
標記方式:Non-conjugated
本頁面中的產品,IL34 Antibody (CSB-PA751146LA01HU),的標記方式是Non-conjugated。對于IL34 Antibody,我們還提供其他標記。見下表:
-
克隆類型:Polyclonal
-
抗體亞型:IgG
-
純化方式:>95%, Protein G purified
-
濃度:It differs from different batches. Please contact us to confirm it.
-
保存緩沖液:Preservative: 0.03% Proclin 300
Constituents: 50% Glycerol, 0.01M PBS, pH 7.4 -
產品提供形式:Liquid
-
應用范圍:ELISA, WB, IHC
-
推薦稀釋比:
Application Recommended Dilution WB 1:500-1:5000 IHC 1:20-1:200 -
Protocols:
-
儲存條件:Upon receipt, store at -20°C or -80°C. Avoid repeated freeze.
-
貨期:Basically, we can dispatch the products out in 1-3 working days after receiving your orders. Delivery time maybe differs from different purchasing way or location, please kindly consult your local distributors for specific delivery time.
-
用途:For Research Use Only. Not for use in diagnostic or therapeutic procedures.
相關產品
靶點詳情
-
功能:Cytokine that promotes the proliferation, survival and differentiation of monocytes and macrophages. Promotes the release of proinflammatory chemokines, and thereby plays an important role in innate immunity and in inflammatory processes. Plays an important role in the regulation of osteoclast proliferation and differentiation, and in the regulation of bone resorption. Signaling via CSF1R and its downstream effectors stimulates phosphorylation of MAPK1/ERK2 AND MAPK3/ERK1.
-
基因功能參考文獻:
- Study found that high IL-34 levels in synovial fluid were significantly associated with the radiographic and symptomatic severity of knee osteoarthritis. PMID: 30159102
- Data showed that single expression of M-CSF or IL-34 can be observed in lung cancer tissues and correlated with poor survival. Additionally, their high co-expression correlates with disease stages and poor survival. Thus, evaluating the expression of both M-CSF and IL-34 may help to estimate disease progression and malignant degree in lung cancer patients. PMID: 29323162
- this study shows that IL-34 regulates IL-6 and IL-8 production in human lung fibroblasts via MAPK, PI3K-Akt, JAK and NF-kappaB signaling pathways PMID: 29857241
- Study indicates that IL-34 can be an indicator of liver inflammation and fibrosis in patients with chronic hepatitis B virus infection. PMID: 29599606
- In conclusion, elevated serum IL-34 levels were demonstrated to be independently associated with renal insufficiency and coronary artery disease in patients with chronic heart failure, regardless of the systolic function. PMID: 27982136
- Data indicate that the interleukin 34 (IL-34) is a feasible diagnostic marker of liver fibrosis in non-alcoholic fatty liver disease (NAFLD) patients. PMID: 27363523
- Findings uncover a novel function for IKKbeta/mHTTx1 interactions in regulating IL-34 production, and implicate a role for IL-34 in non-cell-autonomous, microglial-dependent neurodegeneration in HD. PMID: 28973132
- The IL-34/STAT3/miR-21 pathway is crucial for the survival of synovial fibroblasts in rheumatoid arthritis PMID: 27084907
- Data show that both serum interleukin-34 (IL-34) and IL-34 mRNA in mononuclear leukocytes (PBMCs) in chronic hepatitis B virus (HBV) patients was significantly decreased compared to the healthy controls. PMID: 28614380
- pathogenic role for IL34 in mediating immunosuppression and chemoresistance and identify it as a tractable target for anticancer therapy. PMID: 27550451
- The current study aimed to assess the IL-34 expression in response to two members of the transforming growth factor (TGF)-beta family, TGF-beta1 and bone morphogenetic protein (BMP)-2, in synovial fibroblasts from rheumatoid arthritis patients. PMID: 27865758
- The receiver operating characteristic (ROC) curve analysis has shown that IL-34 has more discriminatory power than C-reactive protein (CRP) for the risk of diabetic complications. The cut-off value for IL-34 was established as 91.2 pg/mL. The gist of our research was identification of IL-34 as an additional potential inflammatory biomarker for the prediction of the risk of vascular diabetic complications. PMID: 26849008
- miR-28-5p-IL-34-macrophage feedback loop modulates hepatocellular carcinoma metastasis PMID: 26754294
- findings demonstrated that M-CSF binds to IL-34; molecular docking studies predicted the formation of a heteromeric M-CSF/IL-34 cytokine PMID: 26095744
- These results suggest that IL-34, a novel osteoclastogenic cytokine, plays a role in rheumatoid arthritis-associated joint damage and is a potential biomarker for predicting subsequent radiographic progression in patients with RA. PMID: 25027626
- IL-34 is expressed by human FOXP3+CD45RCloCD8+ and CD4+ Tregs and markedly inhibited alloreactive immune responses. PMID: 26389674
- This paper provides evidence of alternative binding of IL-34 to chondroitin sulphates and syndecan-1 at the cell surface that modulates M-CSFR activation. PMID: 25662098
- In vitro and in vivo experiments indicate that IL-34 expression is regulated by TNF-a and IL-1b and that its overexpression is associated with an increase in osteosarcoma growth and metastasis. PMID: 25471534
- the expression pattern of IL-34 in ileum and colon and suggest IL-34 as a new modulator of inflammation in inflammatory bowel disease PMID: 25896238
- IL-34 is up-regulated in inflammatory bowel disease and suggest a role for this cytokine in sustaining the inflammatory responses in this disease PMID: 25800277
- IL-34 is induced by IL-22 in the inflammatory cascade in response to IAV infection. PMID: 25415279
- IL-34 expression in human gingival fibroblasts, stimulated by TNF-alpha and IL-1beta PMID: 24339952
- potent profibrotic factor in hepatitis C virus liver fibrosis PMID: 25066464
- IL-34 is associated with insulin resistance. PMID: 24712570
- IL-34 promotes the development, survival, and function of microglia and Langerhans cells; therefore, this cytokine may predominately function in brain and skin biology.[review] PMID: 24737461
- Circulating IL-34 levels in rheumatoid arthritis correlated with autoantibody production. PMID: 23996288
- This study is the first to illustrate downstream transcriptional profiles and pathways of IL-34 in comparison with CSF-1 and identify notable differences in CCR2 expression. PMID: 23684409
- These findings suggest that IL-34 may play a role in the pathogenesis of rheumatoid arthritis. PMID: 23421370
- Data suggest that CSF-1R-independent actions of IL-34 via receptor-type protein-tyrosine phosphatase zeta (PTP-zeta) might be considered in evaluating IL-34 roles in development and disease. PMID: 23744080
- the feline CSF-1R was cloned and the responsiveness to CSF-1 and IL-34 from a range of species, was examined. PMID: 23260168
- IL-34 levels were significantly increased in patients with coronary artery disease (CAD), and positively correlated with hs-CRP levels, suggesting that IL-34 may be an independent predictor of CAD. PMID: 23206468
- IL-34 as a nonredundant cytokine for the development of Langerhans cells during embryogenesis as well as for their homeostasis in the adult skin. PMID: 23177320
- Data suggest a discrete role of IL-34 in inflammatory rheumatoid arthritis (RA) diseases. PMID: 22264405
- study identifies IL-34 expression in the synovial tissue of patients with arthritis; this cytokine, as a downstream effector of TNFalpha and IL-1beta, may contribute to inflammation and bone erosions in rheumatoid arthritis PMID: 22039170
- The different spatiotemporal expression of IL-34 and CSF-1 allows for complementary activation of the CSF-1R in developing and adult tissues. PMID: 20504948
- Discovered IL-34 and its receptor CSF1 by functional screening of the extracellular proteome. PMID: 18467591
顯示更多
收起更多
-
亞細胞定位:Secreted.
-
蛋白家族:IL-34 family
-
組織特異性:Detected in the sinusoidal epithelium in the red pulp of spleen (at protein level). Predominantly expressed in spleen. Also detected in a range of other tissues including heart, brain, lung, liver, kidney, thymus, testis, ovary, small intestine, prostate
-
數據庫鏈接:
Most popular with customers
-
-
YWHAB Recombinant Monoclonal Antibody
Applications: ELISA, WB, IHC, IF, FC
Species Reactivity: Human, Mouse, Rat
-
-
-
-
-
-